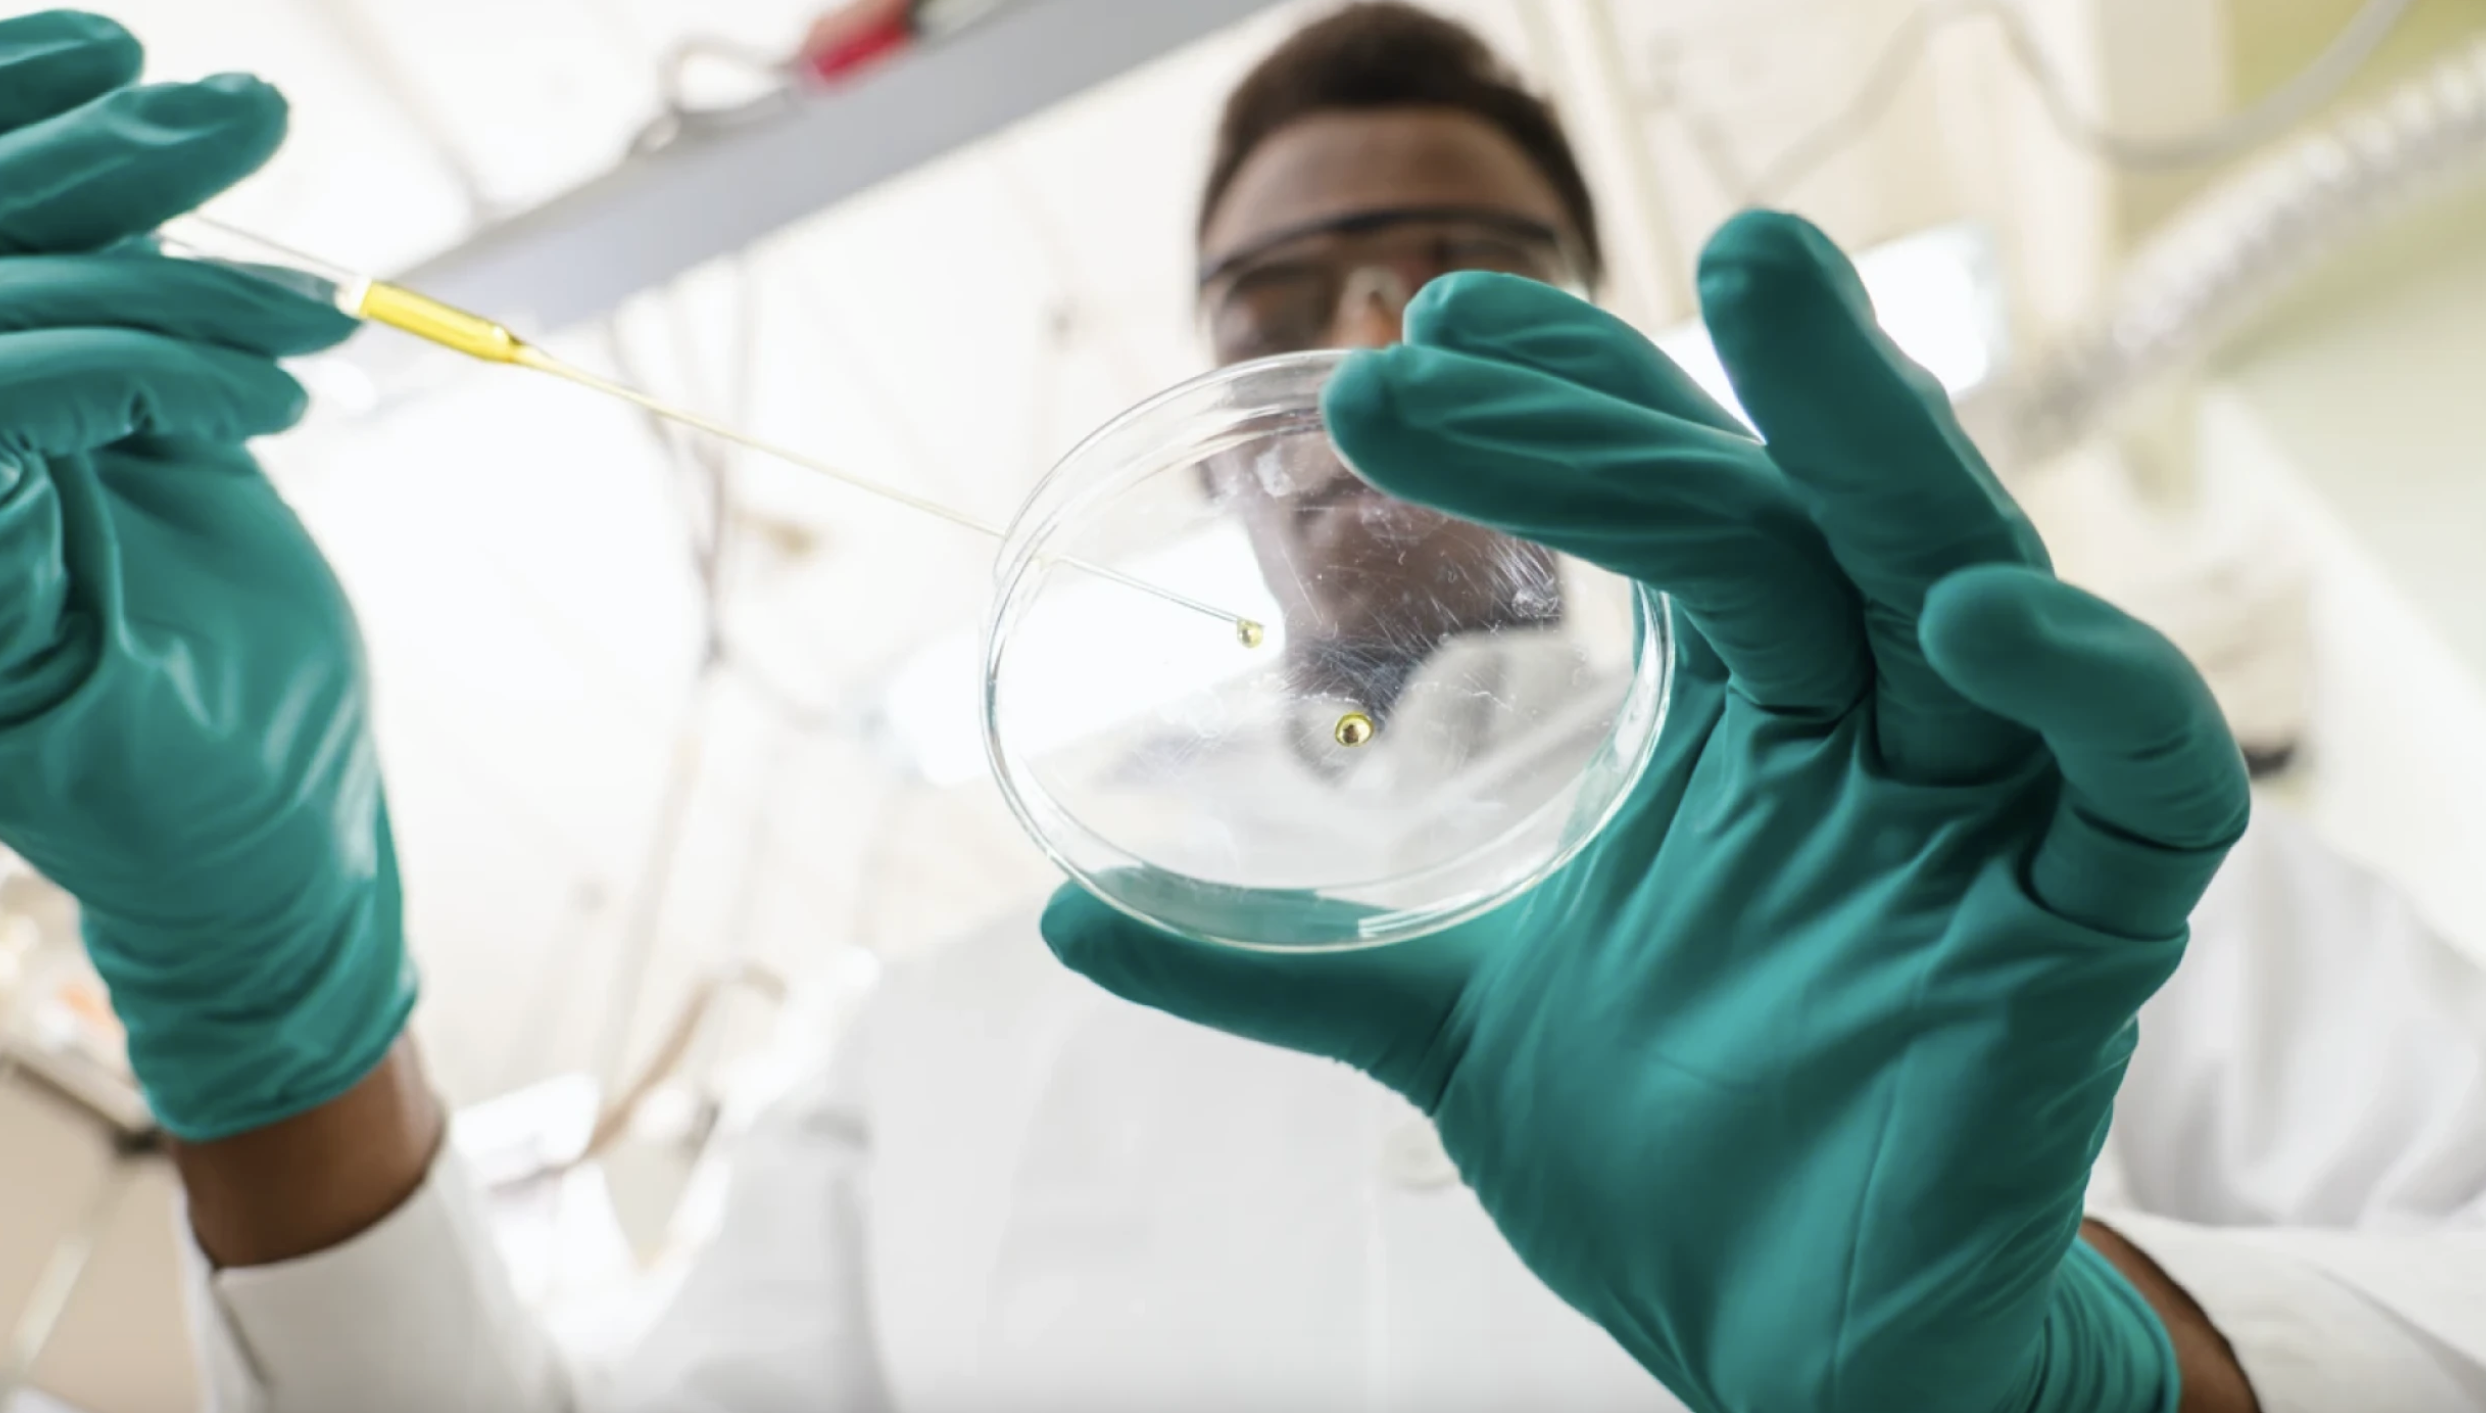

Register Now First Name: Last Name: Email Address: Resume: City: State:
Alabama
Alaska
Arizona
Arkansas
California
Colorado
Connecticut
Delaware
District Of Columbia
Florida
Georgia
Hawaii
Idaho
Illinois
Indiana
Iowa
Kansas
Kentucky
Louisiana
Maine
Maryland
Massachusetts
Michigan
Minnesota
Mississippi
Missouri
Montana
Nebraska
Nevada
New Hampshire
New Jersey
New Mexico
New York
North Carolina
North Dakota
Ohio
Oklahoma
Oregon
Pennsylvania
Puerto Rico
Rhode Island
South Carolina
South Dakota
Tennessee
Texas
Utah
Vermont
Virgin Islands
Virginia
Washington
West Virginia
Wisconsin
Wyoming
Phone: (optional for text/sms reminders)
Current Employer: Current Job Title: Undergrad College:
- College Not Listed -
Academy of Art Col
Acadia Univ
Adams St Col
Adelphi Univ
Air Force Inst of Tech
Alabama A&M University
Alabama State University
Alaska Pacific Univ
Albany State University
Alcorn State University
Alfred Univ
Allegheny Col
Allegheny Univ of Health Sci
Allen University
Amer Grad School, Int`l Mgmt
American Univ
Amherst Col
Andrews Univ
Appalachian St Univ
Arizona St Univ
Arizona St Univ West
Arkansas Baptist College
Arkansas St Univ
Arkansas Tech Univ
Athena Univ
Athens St Col
Auburn Univ
Augusta St Univ
Augustana Col, Rock Island IL
Austin Col
Austin Peay St Univer
Babson Col
Baker Univ
Ball St Univ
Barber-Scotia College
Bates Col
Baylor Col of Dentistry
Baylor Col of Medicine
Baylor Univ
Bellarmine University
Bellevue Univ
Belmont Univ
Benedict College
Bennett College
Bennington Col
Bentley Col
Bernard M. Baruch College
Bethany Col, Lindsborg, KS
Bethany Col, Scotts Valley, CA
Bethany Col, West Virginia
Bethune Cookman University
Birmingham-Southern Col
Bishop College
Bishop State Community College
Bluefield State College
Boise St Univ
Boston Col
Boston University
Bowdoin Col
Bowie State University
Bowling Green St Univ
Bradley Univ
Brandeis Univ
Bridgewater Col
Bridgewater St Col
Brigham Young Univ
Brigham Young Univ Hawaii
Brown University
Bryant Col
Bryn Mawr Col
Bucknell Univ
Buena Vista Univ
Butler Univ
Cal Col for Health Sciences
Cal Inst of Tech
Cal Inst of the Arts
Cal School of Prof Psych
Cal St Polytechnic Univ Pomona
Cal St Polytechnic Univ SLO
Cal St Univ, Bakersfield
Cal St Univ, Chico
Cal St Univ, Dominguez Hills
Cal St Univ, Fresno
Cal St Univ, Fullerton
Cal St Univ, Hayward
Cal St Univ, Long Beach
Cal St Univ, Los Angeles
Cal St Univ, Monterey
Cal St Univ, Northridge
Cal St Univ, Sacramento
Cal St Univ, San Bernadino
Cal St Univ, San Marcos
Cal St Univ, Stanislaus
Cal Univ of Penn
California Coast Univ
Calvin Col
Campbell Univ
Canisius Col
Capella University
Capital Univ
Capitol Col
Carleton Univ
Carnegie Mellon Univ
Carroll University
Carver Career and Tech Ed Ctr
Case Western Reserve Univ
Central Col
Central Conn St Univ
Central Methodist Col
Central Michigan Univ
Central Missouri St Univ
Central State University
Central Texas College
Central Washington Univ
Chaminade Univ of Honolulu, HI
Champlain Col
Chapman Univ
Charles Drew University
Charleston Southern Univ
Chatham Col
Cheyney University of Pennsylvania
Chicago State University
Chicago-Kent Col of Law
Christian Brothers Univ
City Univ, Seattle Wash
Claflin University
Claremont McKenna Col
Clarion Univ
Clark Atlanta University
Clark Univ
Clarkson Univ
Clayton St Col
Clemson Univ
Cleveland St Univ
Clinton College
Coahoma Community College
Coastal Carolina Univ
Col of Aeronautics
Col of Charleston
Col of Notre Dame, San Mateo
Col of St. Benedict
Col of St. Catherine
Col of St. Scholastica
Col of the Atlantic
Col of the Holy Cross
Col of William and Mary
Colby Col
College Not Listed
Colorado Christian Univ
Colorado Col
Colorado St Univ
Columbia Col
Columbia Southern University
Columbia Univ
Columbus State Community College
Concordia College
Concordia Univ
Connecticut Col
Cooper Union
Coppin State University
Cornell Col, Iowa
Cornell Univ
Cornerstone Univesity
Creighton Univ
CUNY - Sophie Davis School of Biomedical Ed
CUNY -Borough of Manhattan Community College
CUNY -Bronx Community College
CUNY -Brooklyn College
CUNY -College of Staten Island
CUNY -Hostos Community College
CUNY -Hunter College
CUNY -John Jay College of Criminal Justice
CUNY -Kingsborough Community College
CUNY -LaGuardia Community College
CUNY -Lehman College
CUNY -Macaulay Honors College
CUNY -New York City College of Technology
CUNY -Queens College
CUNY -Queensborough Community College
CUNY -The City College
CUNY -The CUNY Graduate School of Journalism
CUNY -The CUNY School of Law
CUNY -The CUNY School of Professional Studies
CUNY -The Graduate Center
CUNY -The Medgar Evers College
CUNY -The Teacher Academy
CUNY -York College
Dalhousie Univ
Dallas Baptist Univ
Daniel Webster Col
Dartmouth Col
Davenport Col
Davidson Col
Delaware State University
Denmark Technical College
DePaul Univ
DeVry University
Dickinson Col
Dickinson St Univ
Dillard University
Drew Univ
Drexel Univ
Duquesne Univ
East Carolina Univ
East Stroudsburg St Univ
East Tennessee St Univ
Eastern Col
Eastern Conn St Univ
Eastern Illinois Univ
Eastern Kentucky Univ
Eastern Michigan Univ
Eastern New Mexico Univ
Eastern Washington Univ
Edward Waters University
Elizabeth City State University
Elon University
Emerson Col
Emmaus Bible Col
Emory Univ
Fairfield Univ
Fairleigh Dickinson Univ
Fairmont St Col
Fayetteville State University
Fisk University
Florida A&M University
Florida Atlantic Univ
Florida Gulf Coast Univ
Florida Inst of Tech
Florida Int`l Univ
Florida Memorial University
Florida St Univ
Fordham Univ
Fort Valley State University
Franklin University
Fresno Pacific Col
Full Sail University
Gadsden State Community College
Geneva Col
George Mason Univ
George Washington Univ
Georgetown Col
Georgetown Univ
Georgia Col
Georgia Inst of Tech
Georgia Southern Univ
Georgia Southwestern Col
Georgia St Univ
Gettysburg Col
Gonzaga Univ
Grambling State University
Guadalupe College
Hamilton Col
Hampshire Col
Hampton University
Hanover Col
Harris-Stowe State University
Harvard Univ
Harvey Mudd Col
Haverford Col
Hawaii Pacific Univ
Heald Business College
Hebrew Col
Hinds Community College
Hofstra Univ
Howard University
Humboldt St Univ
Huston-Tillotson University
Idaho St Univ
Illinois Inst of Tech
Illinois St Univ
Illinois Wesleyan Univ
IN Univ, Purdue Univ, Ft Wayne
IN Univ, Purdue Univ, Indianap
Indiana Inst Tech
Indiana St Univ
Indiana Univ
Indiana Univ of Penn
Indiana Wesleyan Univ
Interdenominational Theological Center
Iona Col
Iowa St Univ
Ivy Tech Community College
J.F. Drake State Technical College
Jackson State University
Jacksonville St Univ
Jacksonville Univ
James Madison Univ
Jamestown Col
Jarvis Christian College
Jersey City St Col
John F. Kennedy Univ
Johnson C. Smith University
Juniata Col
Kalamazoo Col
Kansas City Kansas Community College
Kansas St Univ
Kean University
Keene St Col
Keller Graduate School of Management
Kent State University
Kentucky Christian Univ
Kentucky State University
Kentucky Wesleyan Col
Knoxville College
La Salle Univ
La Sierra University
Lafayette Col
Lake Superior St Univ
Lane College
Langston University
Lawson State Community College
Lehigh Univervsity
LeMoyne-Owen College
Lewis and Clark Col
Lewis College of Business
Lewis-Clark St Col
Lincoln University -Missouri
Lincoln University -Pennsylvania
Livingstone College
Long Island Univ
Louisiana Col
Louisiana St Univ at Shreveport
Louisiana Tech Univ
Loyola Col, Baltimore
Loyola Marymount Univ
Loyola Univ, Chicago
Loyola Univ, New Orleans
LS St Univ at Baton Rouge
Maine Maritime Academy
Marist Col
Marquette Univ
Mary Holmes College
Maryland Inst, Col of Art
Marymount Univ
Mass Inst of Tech
Mass Maritime Academy
McGill Univ
McMaster Univ
Med Col of Penn and Hahnemann U
Medical Col of Georgia
Medical Col of Ohio
Medical Col of Wisconsin
Medical Univ of South Carolina
Meharry Medical College
Mercy College
Meredith College
Miami Univ of Ohio
Michigan St Univ
Middle Tennessee State University
Middlebury Col
Midway College
Miles College
Milwaukee School of Engineering
Minn. Col of Art and Design
Mississippi Col
Mississippi St Univ
Mississippi Univ for Women
Mississippi Valley State University
Missouri Southern St Col
Missouri Western St Col
Molloy Col
Monroe College
Montana St Univ-Billings
Montana St Univ-Bozeman
Montana St Univ-Northern Havre
Montana Tech
Montclair St Univ
Moorhead St Univ
Morehead St Univ
Morehouse College
Morehouse School of Medicine
Morgan State University
Morris Brown College
Morris College
Mount Hermon Female Seminary
Mount Holyoke Col
Murray St Univ
N Carolina St Univ
N Carolina Wesleyan Col
N Dakota St Univ--Bottineau
N Dakota St Univ--Fargo
N Dakota Univ System
N/A
New Hampshire Col
New Jersey Inst of Tech
New Mexico Highlands Univ
New Mexico St Univ
New Mexico Western Univ
New School for Social Research
New York Inst of Tech
New York Univ
Niagara Univ
NM Inst of Mining and Tech
Norfolk State University
North Carolina A&T State University
North Carolina Central University
Northeastern Univ
Northern Arizona Univ
Northern Illinois Univ
Northern Kentucky Univ
Northwestern Christian University
Northwestern Univ
Norwich Univ
Oakland Univ
Oakwood University
Occidental Col
Ohio Dominican University
Ohio Northern Univ
Ohio Univ
Ohio Wesleyn
Oklahoma Baptist Univ
Oklahoma Christian Univ
Oklahoma St Univ
Old Dominion Univ
Oral Roberts Univ
Oregon Inst of Tech
Oregon St Univ
Ottawa College
Pace Univ
Pacific Lutheran Univ
Pacific Union Col
Pacific Univ
Paine College
Palm Beach State
Paul Quinn College
Penn St Univ
Pepperdine Univ
Philander Smith College
Piedmont Col
Pittsburg St Univ
Polytechnic Univ of NY
Polytechnic Univ of PR
Pomona Col
Portland St Univ
Prairie View A&M University
Pratt Inst
Prince Georges Community College
Princeton Univ
Providence Col
Purdue Univ
Queen`s Univ
Rensselaer Polytechnic Inst
Rhode Island Col
Rhode Island School of Design
Rhodes Col
Rice Univ
Rider University
Rochester Inst of Tech
Rust College
Rutgers Univ
Rutgers Univ-Camden
Rutgers Univ-Newark
Ryerson Polytechnic Univ
S Dakota St Univ
Sacred Heart Univ
Saginaw Valley St Univ
Saint Augustines College
Saint Pauls College
Salem Col
Sam Houston State University
San Diego St Univ
San Francisco St Univ
San Jose St Univ
Santa Clara Univ
Savannah College of Art and Design
Savannah State University
School of the Visual Arts
SD School of Mines and Tech
Seattle Pacific Univ
Seattle Univ
Selma University
Seton Hall Univ
Shaw University
Shelton State Community College
Shorter College
Simmons College in Boston
Simmons College of Kentucky
Simon Fraser University
Skidmore Col
Smith College
Sojourner-Douglass College
Sonoma St Univ
South Carolina State University
Southampton Col
Southeast Missouri St Univ
Southeastern Louisiana Univ
Southern California Col
Southern Col
Southern Col of Tech
Southern Connecticut St Univ
Southern IL Univ at Carbondale
Southern Methodist Univ
Southern Oregon St Col
Southern University and A&M College
Southern University at New Orleans
Southern University at Shreveport
Southern Utah Univ
Southern Vermont Col
Southern Wesleyan Univ
Southwest Baptist Univ
Southwest Missouri St Univ
Southwest St Univ
Southwest Texas St Univ
Southwestern Adventist Col
Southwestern Christian College
Southwestern Univ
Southwestern Univ School of Law
Spelman College
Spring Arbor Col
Spring Hill Col
St Univ of West Georgia
St. Ambrose Univ
St. Andrews Presb Col
St. Anselm Col
St. Bonaventure Univ
St. Cloud St Univ
St. Edwards Univ
St. Francis Col
St. John`s Col
St. John`s Univ, Jamaica NY
St. John`s Univ, Minnesota
St. Joseph Col
St. Joseph`s Col
St. Joseph`s Univ
St. Lawrence Univ
St. Leo Col
St. Mary`s Col
St. Mary`s Col of Cal
St. Mary`s Col of Maryland
St. Mary`s Col of Minnesota
St. Mary`s Univ of San Antonio
St. Michael`s Col
St. Norbert Col
St. Olaf Col
St. Philips College
St. Thomas Univ
St. Xavier Univ
Stanford Univ
Stephen F. Austin State University
Stephens Col
Stetson Univ
Stevens Inst of Tech
Stillman College
Storer College
Straight University (College)
Strayer University
Suffolk Univ
Suny at Albany
Suny at Binghamton
Suny at Buffalo
Suny at Cobleskill
Suny at Old Westbury
Suny at Oswego
Suny at Stony Brook
Suny Col at Brockport
Suny Col at Buffalo
Suny Col at Cortland
Suny Col at Farmingdale
Suny Col at Fredonia
Suny Col at Geneseo
Suny Col at New Paltz
Suny Col at Oneonta
Suny Col at Plattsburgh
Suny Col at Potsdam
Suny Inst of Tech at Utica/Rome
Swarthmore Col
Syracuse Univ
Talladega College
Temple Univ
Tennessee State University
Tennessee Technological Univ
Texas A and M Int`l Univ
Texas A and M Univ
Texas A and M Univ, Commerce
Texas A and M Univ, Corpus Christi
Texas A and M Univ, Kingsville
Texas Christian Univ
Texas College
Texas Southern University
Texas Tech Univ
Texas Woman`s Univ
The American Col
The Art Institute of California - Los Angeles
The Boston Archit Center
The Cal Maritime Academy
The Catholic Univ of America
The Citadel
The Claremont Graduate School
The Col of New Jersey
The Johns Hopkins Univ
The Ohio St Univ
Thomas Col
Thomas Cooley Law School
Thomas Edison St Col
Thomas Jefferson Univ
Tougaloo College
Towson University
Transylvania Univ
Trenholm State Community College
Trinity Col
Trinity Int`l Univ
Trinity Univ
Tufts University
TUI University
Tulane Univ
Tuskegee University
UC, Berkeley
UC, Davis
UC, Hastings Col of Law
UC, Irvine
UC, Los Angeles
UC, Office of the President
UC, Riverside
UC, San Diego
UC, San Francisco
UC, Santa Barbara
UC, Santa Cruz
Union Col
University of Alabama
University of Alabama, Birmingham
University of Alabama, Huntsville
University of Alaska System
University of Alaska, Anchorage
University of Alaska, Fairbanks
University of Alberta
University of Arizona
University of Arkansas at Pine Bluff
University of Arkansas, Fayetteville
University of Arkansas, Little Rock
University of Arkansas, Monticello
University of Baltimore
University of Bridgeport
University of British Columbia
University of Calgary
University of Central Arkansas
University of Central Florida
University of Central Oklahoma
University of Charleston
University of Chicago
University of Cincinnati
University of Colorado
University of Colorado, CO Springs
University of Colorado, Denver
University of Connecticut
University of Dallas
University of Dayton
University of Delaware
University of Denver
University of Detroit Mercy
University of Dubuque
University of Evansville
University of Florida
University of Georgia
University of Guam
University of Guelph
University of Hartford
University of Hawaii
University of Houston
University of Houston, Clear Lake
University of Idaho
University of Ill at Chicago
University of Ill at Springfield
University of Ill at Urbana-Champaign
University of Indianapolis
University of Iowa
University of Judaism
University of Kansas
University of Kansas Medical Center
University of Kentucky
University of Louisville
University of Maine
University of Maine at Ft Kent
University of Maine System
University of Manitoba
University of Maryland at Baltimore
University of Maryland at Col Park
University of Maryland Eastern Shore
University of Maryland System
University of Maryland, Balt County
University of Mass at Amherst
University of Mass at Boston
University of Mass at Dartmouth
University of Mass at Lowell
University of Mass System
University of Med and Dentistry NJ
University of Memphis
University of Miami
University of Michigan-Ann Arbor
University of Michigan-Dearborn
University of Minnesota-Crookston
University of Minnesota-Duluth
University of Minnesota-Morris
University of Minnesota-Twin Cities
University of Mississippi
University of Missouri-Columbia
University of Missouri-Kansas City
University of Missouri-Rolla
University of Missouri-St. Louis
University of Montana, Missoula
University of N Dakota
University of N Dakota--Lake Region
University of N Florida
University of N Texas
University of NC at Asheville
University of NC at Chapel Hill
University of NC at Charlotte
University of NC at Greensboro
University of NC at Wilmington
University of Nebraska, Kearney
University of Nebraska, Lincoln
University of Nebraska, Omaha
University of Nevada Las Vegas
University of Nevada Reno
University of Nevada System
University of New Bruns., Fredericton
University of New Bruns., St John
University of New England
University of New Hamp, Durham
University of New Haven
University of New Mexico
University of New Orleans
University of Newport
University of North Texas
University of Northern Brit. Col.
University of Northern Colorado
University of Northern Iowa
University of Notre Dame
University of Oklahoma
University of Oregon
University of Ottawa
University of Penn
University of Phoenix
University of Pitt
University of Pitt at Johnstown
University of Portland
University of PR
University of PR, Mayaguez
University of PR, Rio Piedras
University of Puget Sound
University of Redlands
University of Regina
University of Rhode Island
University of Richmond
University of Rochester
University of S Alabama
University of S Carolina
University of S Carolina Upstate
University of S Carolina, Aiken
University of S Dakota
University of S Florida
University of San Diego
University of San Francisco
University of Saskatchewan
University of Scranton
University of Southern Cal
University of Southern CO
University of Southern Indiana
University of Southern Maine
University of Southern Mississippi
University of St. Thomas, Houston
University of St. Thomas, St. Paul
University of SW Louisiana
University of Tampa
University of Tenn, Chattanooga
University of Tenn, Knoxville
University of Tenn, Martin
University of Tenn, Memphis
University of Texas at El Paso
University of the District of Columbia
University of the Pacific
University of the South
University of the Virgin Islands
University of Toledo
University of Toronto
University of Tulsa
University of Utah
University of Vermont
University of Victoria
University of Virginia
University of W-Stevens Point
University of Washington
University of Waterloo
University of West Alabama
University of West Florida
University of West Georgia
University of Western Ontario
University of Winnipeg
University of Wisconsin-Eau Claire
University of Wisconsin-Green Bay
University of Wisconsin-La Crosse
University of Wisconsin-Madison
University of Wisconsin-Milwaukee
University of Wisconsin-Oshkosh
University of Wisconsin-Parkside
University of Wisconsin-Platteville
University of Wisconsin-River Falls
University of Wisconsin-Stout
University of Wisconsin-Superior
University of Wisconsin-Whitewater
University of Wyoming
Upper Iowa Univ
Ursinus Col
US Air Force Academy
US Coast Guard Academy
US Int`l Univ
US Merchant Marine Academy
US Military Academy
US Naval Academy
US Sports Academy
UT at Arlington
UT at Austin
UT at Brownsville
UT at Dallas
UT at Houston
UT at San Antonio
UT at Tyler
UT Health Center at Tyler
UT Medical Branch
UT SW Medical Center
UT-Pan American
Utah St Univ
Utah Valley St Col
Valdosta St Univ
Valley City St Univ
Valparaiso Univ
Vanderbilt Univ
Vassar Col
Vermont Technical Col
Villanova Univ
Virginia Commonwealth Univ
Virginia Military Inst
Virginia State University
Virginia Tech
Virginia Union University
Virginia University of Lynchburg
Virginia Wesleyan Col
Voorhees College
Wagner Col
Walden Univ
Warner University
Wartburg Col
Washington and Lee Univ
Washington Col
Washington St Univ
Washington Univ in St. Louis
Wayne St Univ
Weber St Univ
Webster Univ
Wellesley Col
Wentworth Inst of Tech
Wesley Col
Wesleyan College
Wesleyan Univ
West Texas A and M Univ
West Virginia State University
West Virginia Univ
Western Baptist Col
Western Carolina Univ
Western Conn St Univ
Western Illinois Univ
Western Kentucky Univ
Western Maryland Col
Western Michigan Univ
Western Montana Col
Western New England Col
Western Oregon St Col
Western St Col
Western Washington Univ
Wichita St Univ
Wilberforce University
Wiley College
Wilfrid Laurier Univ
Williams Col
Wilmington University
Winston-Salem State University
Wright State Univ
Xavier Univ, Cinci, OH
Xavier University of Louisiana
Yale Univ
Yeshiva Univ
York Univ
Undergrad Major:
Accounting
Actuarial Science
Advertising
Aerospace Engineering
African Studies
African-American Studies
Agricultural Business and Management
Agricultural Economics
Agricultural Education
Agricultural Engineering
Agricultural Journalism
Agricultural Mechanization
Agricultural Technology Management
Agriculture
Agronomy
Air Force R.O.T.C.
American History
American Literature
American Studies
Animal Science
Anthropology
Applied Mathematics
Applied Physics
Arabic
Archeology
Architectural Engineering
Architectural History
Architecture
Army R.O.T.C.
Art
Art Education
Art History
Asian-American Studies
Astronomy
Astrophysics
Atmospheric Science
Aviation
Bakery Science
Biblical Studies
Biochemistry
Bioengineering
Biology
Biopsychology
Botany
Business Administration
Business Communications
Business Information Systems
Business Intelligence
Cell Biology
Ceramic Engineering
Ceramics
Chemical Engineering
Chemistry
Child Care
Child Development
Chinese
Chiropractic
Church Music
Circulation Technology
Civil Engineering
Classics
Clinical Psychology
Communication
Communication Disorders
Comparative Literature
Computer and Information Science
Computer Engineering
Computer Hardware Engineering
Computer Software Engineering
Computer Systems Analysis
Construction Management & Safety
Counseling
Creative Writing
Criminal Justice
Criminology
Crop Science
Culinary Arts
Dance
Data Processing
Developmental Psychology
Dietetics
Drawing
Early Childhood Education
East Asian Studies
East European Studies
Ecology
Economics
Education
Education Administration
Education of the Deaf
Educational Psychology
Electrical Engineering
Electronics
Electronics and Computer Technology
Elementary Education
Engineering Design
Engineering Mechanics
English
English Composition
English Literature
Entomology
Entrepreneurship
Environmental Engineering
Environmental Health Engineering
Environmental Science
Experimental Psychology
Fashion Design
Feed Science
Film
Finance
Food Science
Forensic Science
Forestry
French
General Studies
Genetics
Geography
Geological Engineering
Geology
German
Gerontology
Grain Science
Graphic Art
Great Books
Health Administration
Health Information Management
Hebrew
Historic Preservation
History
Home Economics
Horticulture
Hospitality
Human Development
Human Resources Management
Industrial Design
Industrial Engineering
Industrial Management
Industrial Psychology
Industrial Technology
Information Technology
Instructional Technology
Insurance
Interior Architecture
Interior Design
International Agriculture
International Business
International Relations
International Studies
Islamic Studies
Italian
Japanese
Jazz Studies
Jewish Studies
Journalism
Kinesiology
Landscape Architecture
Landscape Horticulture
Latin American Studies
Law
Library Science
Linguistics
Logistics Management
Management
Management Information Systems
Managerial Economics
Manufacturing Systems
Marine Corps R.O.T.C.
Marine Science
Marketing
Mass Communication
Mass Media Arts
Materials Science
Mathematics
Mechanical Engineering
Medical Technology
Medicine
Medieval and Renaissance Studies
Mental Health Services
Metallurgical Engineering
Microbiology
Middle Eastern Studies
Military Science
Mineral Engineering
Missions
Modern Greek
Molecular Genetics
Mortuary Science
Museum Studies
Music
Music History
Natural Resources Conservation
Naval Architecture
Navy R.O.T.C.
Neurobiology
Neuroscience
Nuclear Engineering
Nursing
Nutrition
Occupational Therapy
Ocean Engineering
Operations Management
Painting
Pastoral Studies
Peace Studies
Petroleum Engineering
Pharmacology
Pharmacy
Philosophy
Photography
Physical Education
Physical Therapy
Physics
Physiological Psychology
Piano
Plant Biology
Plant Pathology
Political Science
Portuguese
Poultry Science
Pre-Dentistry
Pre-Law
Pre-Medicine
Pre-Optometry
Pre-Seminary
Pre-Veterinary Medicine
Printmaking
Psychology
Public Administration
Public Health
Public Policy Analysis
Public Relations
Radio and Television
Radiologic Technology
Real Estate
Recreation Management
Rehabilatation Services
Religious Studies
Respiratory Therapy
Rhetoric
Risk Management
Rural Sociology
Russian
Sculpture
Slavic Languages and Literatures
Social Psychology
Social Work
Sociology
Soil Science
South Asian Studies
Southeast Asia Studies
Spanish
Special Education
Speech Pathology
Sport and Leisure Studies
Statistics
Substance Abuse Counseling
Surveying
Sustainable Resource Management
Teacher Education
Teaching English as a Second Language
Technical Writing
Technology Education
Telecommunications
Textile Engineering
Theatre
Theology
Turfgrass Science
Undecided
Urban Planning
Urban Studies
Visual Communication
Voice
Welding Engineering
Wildlife Management
Womens Studies
Youth Ministries
Zoology
Graduating Class: (optional)
1950
1951
1952
1953
1954
1955
1956
1957
1958
1959
1960
1961
1962
1963
1964
1965
1966
1967
1968
1969
1970
1971
1972
1973
1974
1975
1976
1977
1978
1979
1980
1981
1982
1983
1984
1985
1986
1987
1988
1989
1990
1991
1992
1993
1994
1995
1996
1997
1998
1999
2000
2001
2002
2003
2004
2005
2006
2007
2008
2009
2010
2011
2012
2013
2014
2015
2016
2017
2018
2019
2020
2021
2022
2023
2024
2025
2026
2027
2028
2029
Grad School: (optional)
- College Not Listed -
Academy of Art Col
Acadia Univ
Adams St Col
Adelphi Univ
Air Force Inst of Tech
Alabama A&M University
Alabama State University
Alaska Pacific Univ
Albany State University
Alcorn State University
Alfred Univ
Allegheny Col
Allegheny Univ of Health Sci
Allen University
Amer Grad School, Int`l Mgmt
American Univ
Amherst Col
Andrews Univ
Appalachian St Univ
Arizona St Univ
Arizona St Univ West
Arkansas Baptist College
Arkansas St Univ
Arkansas Tech Univ
Athena Univ
Athens St Col
Auburn Univ
Augusta St Univ
Augustana Col, Rock Island IL
Austin Col
Austin Peay St Univer
Babson Col
Baker Univ
Ball St Univ
Barber-Scotia College
Bates Col
Baylor Col of Dentistry
Baylor Col of Medicine
Baylor Univ
Bellarmine University
Bellevue Univ
Belmont Univ
Benedict College
Bennett College
Bennington Col
Bentley Col
Bernard M. Baruch College
Bethany Col, Lindsborg, KS
Bethany Col, Scotts Valley, CA
Bethany Col, West Virginia
Bethune Cookman University
Birmingham-Southern Col
Bishop College
Bishop State Community College
Bluefield State College
Boise St Univ
Boston Col
Boston University
Bowdoin Col
Bowie State University
Bowling Green St Univ
Bradley Univ
Brandeis Univ
Bridgewater Col
Bridgewater St Col
Brigham Young Univ
Brigham Young Univ Hawaii
Brown University
Bryant Col
Bryn Mawr Col
Bucknell Univ
Buena Vista Univ
Butler Univ
Cal Col for Health Sciences
Cal Inst of Tech
Cal Inst of the Arts
Cal School of Prof Psych
Cal St Polytechnic Univ Pomona
Cal St Polytechnic Univ SLO
Cal St Univ, Bakersfield
Cal St Univ, Chico
Cal St Univ, Dominguez Hills
Cal St Univ, Fresno
Cal St Univ, Fullerton
Cal St Univ, Hayward
Cal St Univ, Long Beach
Cal St Univ, Los Angeles
Cal St Univ, Monterey
Cal St Univ, Northridge
Cal St Univ, Sacramento
Cal St Univ, San Bernadino
Cal St Univ, San Marcos
Cal St Univ, Stanislaus
Cal Univ of Penn
California Coast Univ
Calvin Col
Campbell Univ
Canisius Col
Capella University
Capital Univ
Capitol Col
Carleton Univ
Carnegie Mellon Univ
Carroll University
Carver Career and Tech Ed Ctr
Case Western Reserve Univ
Central Col
Central Conn St Univ
Central Methodist Col
Central Michigan Univ
Central Missouri St Univ
Central State University
Central Texas College
Central Washington Univ
Chaminade Univ of Honolulu, HI
Champlain Col
Chapman Univ
Charles Drew University
Charleston Southern Univ
Chatham Col
Cheyney University of Pennsylvania
Chicago State University
Chicago-Kent Col of Law
Christian Brothers Univ
City Univ, Seattle Wash
Claflin University
Claremont McKenna Col
Clarion Univ
Clark Atlanta University
Clark Univ
Clarkson Univ
Clayton St Col
Clemson Univ
Cleveland St Univ
Clinton College
Coahoma Community College
Coastal Carolina Univ
Col of Aeronautics
Col of Charleston
Col of Notre Dame, San Mateo
Col of St. Benedict
Col of St. Catherine
Col of St. Scholastica
Col of the Atlantic
Col of the Holy Cross
Col of William and Mary
Colby Col
College Not Listed
Colorado Christian Univ
Colorado Col
Colorado St Univ
Columbia Col
Columbia Southern University
Columbia Univ
Columbus State Community College
Concordia College
Concordia Univ
Connecticut Col
Cooper Union
Coppin State University
Cornell Col, Iowa
Cornell Univ
Cornerstone Univesity
Creighton Univ
CUNY - Sophie Davis School of Biomedical Ed
CUNY -Borough of Manhattan Community College
CUNY -Bronx Community College
CUNY -Brooklyn College
CUNY -College of Staten Island
CUNY -Hostos Community College
CUNY -Hunter College
CUNY -John Jay College of Criminal Justice
CUNY -Kingsborough Community College
CUNY -LaGuardia Community College
CUNY -Lehman College
CUNY -Macaulay Honors College
CUNY -New York City College of Technology
CUNY -Queens College
CUNY -Queensborough Community College
CUNY -The City College
CUNY -The CUNY Graduate School of Journalism
CUNY -The CUNY School of Law
CUNY -The CUNY School of Professional Studies
CUNY -The Graduate Center
CUNY -The Medgar Evers College
CUNY -The Teacher Academy
CUNY -York College
Dalhousie Univ
Dallas Baptist Univ
Daniel Webster Col
Dartmouth Col
Davenport Col
Davidson Col
Delaware State University
Denmark Technical College
DePaul Univ
DeVry University
Dickinson Col
Dickinson St Univ
Dillard University
Drew Univ
Drexel Univ
Duquesne Univ
East Carolina Univ
East Stroudsburg St Univ
East Tennessee St Univ
Eastern Col
Eastern Conn St Univ
Eastern Illinois Univ
Eastern Kentucky Univ
Eastern Michigan Univ
Eastern New Mexico Univ
Eastern Washington Univ
Edward Waters University
Elizabeth City State University
Elon University
Emerson Col
Emmaus Bible Col
Emory Univ
Fairfield Univ
Fairleigh Dickinson Univ
Fairmont St Col
Fayetteville State University
Fisk University
Florida A&M University
Florida Atlantic Univ
Florida Gulf Coast Univ
Florida Inst of Tech
Florida Int`l Univ
Florida Memorial University
Florida St Univ
Fordham Univ
Fort Valley State University
Franklin University
Fresno Pacific Col
Full Sail University
Gadsden State Community College
Geneva Col
George Mason Univ
George Washington Univ
Georgetown Col
Georgetown Univ
Georgia Col
Georgia Inst of Tech
Georgia Southern Univ
Georgia Southwestern Col
Georgia St Univ
Gettysburg Col
Gonzaga Univ
Grambling State University
Guadalupe College
Hamilton Col
Hampshire Col
Hampton University
Hanover Col
Harris-Stowe State University
Harvard Univ
Harvey Mudd Col
Haverford Col
Hawaii Pacific Univ
Heald Business College
Hebrew Col
Hinds Community College
Hofstra Univ
Howard University
Humboldt St Univ
Huston-Tillotson University
Idaho St Univ
Illinois Inst of Tech
Illinois St Univ
Illinois Wesleyan Univ
IN Univ, Purdue Univ, Ft Wayne
IN Univ, Purdue Univ, Indianap
Indiana Inst Tech
Indiana St Univ
Indiana Univ
Indiana Univ of Penn
Indiana Wesleyan Univ
Interdenominational Theological Center
Iona Col
Iowa St Univ
Ivy Tech Community College
J.F. Drake State Technical College
Jackson State University
Jacksonville St Univ
Jacksonville Univ
James Madison Univ
Jamestown Col
Jarvis Christian College
Jersey City St Col
John F. Kennedy Univ
Johnson C. Smith University
Juniata Col
Kalamazoo Col
Kansas City Kansas Community College
Kansas St Univ
Kean University
Keene St Col
Keller Graduate School of Management
Kent State University
Kentucky Christian Univ
Kentucky State University
Kentucky Wesleyan Col
Knoxville College
La Salle Univ
La Sierra University
Lafayette Col
Lake Superior St Univ
Lane College
Langston University
Lawson State Community College
Lehigh Univervsity
LeMoyne-Owen College
Lewis and Clark Col
Lewis College of Business
Lewis-Clark St Col
Lincoln University -Missouri
Lincoln University -Pennsylvania
Livingstone College
Long Island Univ
Louisiana Col
Louisiana St Univ at Shreveport
Louisiana Tech Univ
Loyola Col, Baltimore
Loyola Marymount Univ
Loyola Univ, Chicago
Loyola Univ, New Orleans
LS St Univ at Baton Rouge
Maine Maritime Academy
Marist Col
Marquette Univ
Mary Holmes College
Maryland Inst, Col of Art
Marymount Univ
Mass Inst of Tech
Mass Maritime Academy
McGill Univ
McMaster Univ
Med Col of Penn and Hahnemann U
Medical Col of Georgia
Medical Col of Ohio
Medical Col of Wisconsin
Medical Univ of South Carolina
Meharry Medical College
Mercy College
Meredith College
Miami Univ of Ohio
Michigan St Univ
Middle Tennessee State University
Middlebury Col
Midway College
Miles College
Milwaukee School of Engineering
Minn. Col of Art and Design
Mississippi Col
Mississippi St Univ
Mississippi Univ for Women
Mississippi Valley State University
Missouri Southern St Col
Missouri Western St Col
Molloy Col
Monroe College
Montana St Univ-Billings
Montana St Univ-Bozeman
Montana St Univ-Northern Havre
Montana Tech
Montclair St Univ
Moorhead St Univ
Morehead St Univ
Morehouse College
Morehouse School of Medicine
Morgan State University
Morris Brown College
Morris College
Mount Hermon Female Seminary
Mount Holyoke Col
Murray St Univ
N Carolina St Univ
N Carolina Wesleyan Col
N Dakota St Univ--Bottineau
N Dakota St Univ--Fargo
N Dakota Univ System
N/A
New Hampshire Col
New Jersey Inst of Tech
New Mexico Highlands Univ
New Mexico St Univ
New Mexico Western Univ
New School for Social Research
New York Inst of Tech
New York Univ
Niagara Univ
NM Inst of Mining and Tech
Norfolk State University
North Carolina A&T State University
North Carolina Central University
Northeastern Univ
Northern Arizona Univ
Northern Illinois Univ
Northern Kentucky Univ
Northwestern Christian University
Northwestern Univ
Norwich Univ
Oakland Univ
Oakwood University
Occidental Col
Ohio Dominican University
Ohio Northern Univ
Ohio Univ
Ohio Wesleyn
Oklahoma Baptist Univ
Oklahoma Christian Univ
Oklahoma St Univ
Old Dominion Univ
Oral Roberts Univ
Oregon Inst of Tech
Oregon St Univ
Ottawa College
Pace Univ
Pacific Lutheran Univ
Pacific Union Col
Pacific Univ
Paine College
Palm Beach State
Paul Quinn College
Penn St Univ
Pepperdine Univ
Philander Smith College
Piedmont Col
Pittsburg St Univ
Polytechnic Univ of NY
Polytechnic Univ of PR
Pomona Col
Portland St Univ
Prairie View A&M University
Pratt Inst
Prince Georges Community College
Princeton Univ
Providence Col
Purdue Univ
Queen`s Univ
Rensselaer Polytechnic Inst
Rhode Island Col
Rhode Island School of Design
Rhodes Col
Rice Univ
Rider University
Rochester Inst of Tech
Rust College
Rutgers Univ
Rutgers Univ-Camden
Rutgers Univ-Newark
Ryerson Polytechnic Univ
S Dakota St Univ
Sacred Heart Univ
Saginaw Valley St Univ
Saint Augustines College
Saint Pauls College
Salem Col
Sam Houston State University
San Diego St Univ
San Francisco St Univ
San Jose St Univ
Santa Clara Univ
Savannah College of Art and Design
Savannah State University
School of the Visual Arts
SD School of Mines and Tech
Seattle Pacific Univ
Seattle Univ
Selma University
Seton Hall Univ
Shaw University
Shelton State Community College
Shorter College
Simmons College in Boston
Simmons College of Kentucky
Simon Fraser University
Skidmore Col
Smith College
Sojourner-Douglass College
Sonoma St Univ
South Carolina State University
Southampton Col
Southeast Missouri St Univ
Southeastern Louisiana Univ
Southern California Col
Southern Col
Southern Col of Tech
Southern Connecticut St Univ
Southern IL Univ at Carbondale
Southern Methodist Univ
Southern Oregon St Col
Southern University and A&M College
Southern University at New Orleans
Southern University at Shreveport
Southern Utah Univ
Southern Vermont Col
Southern Wesleyan Univ
Southwest Baptist Univ
Southwest Missouri St Univ
Southwest St Univ
Southwest Texas St Univ
Southwestern Adventist Col
Southwestern Christian College
Southwestern Univ
Southwestern Univ School of Law
Spelman College
Spring Arbor Col
Spring Hill Col
St Univ of West Georgia
St. Ambrose Univ
St. Andrews Presb Col
St. Anselm Col
St. Bonaventure Univ
St. Cloud St Univ
St. Edwards Univ
St. Francis Col
St. John`s Col
St. John`s Univ, Jamaica NY
St. John`s Univ, Minnesota
St. Joseph Col
St. Joseph`s Col
St. Joseph`s Univ
St. Lawrence Univ
St. Leo Col
St. Mary`s Col
St. Mary`s Col of Cal
St. Mary`s Col of Maryland
St. Mary`s Col of Minnesota
St. Mary`s Univ of San Antonio
St. Michael`s Col
St. Norbert Col
St. Olaf Col
St. Philips College
St. Thomas Univ
St. Xavier Univ
Stanford Univ
Stephen F. Austin State University
Stephens Col
Stetson Univ
Stevens Inst of Tech
Stillman College
Storer College
Straight University (College)
Strayer University
Suffolk Univ
Suny at Albany
Suny at Binghamton
Suny at Buffalo
Suny at Cobleskill
Suny at Old Westbury
Suny at Oswego
Suny at Stony Brook
Suny Col at Brockport
Suny Col at Buffalo
Suny Col at Cortland
Suny Col at Farmingdale
Suny Col at Fredonia
Suny Col at Geneseo
Suny Col at New Paltz
Suny Col at Oneonta
Suny Col at Plattsburgh
Suny Col at Potsdam
Suny Inst of Tech at Utica/Rome
Swarthmore Col
Syracuse Univ
Talladega College
Temple Univ
Tennessee State University
Tennessee Technological Univ
Texas A and M Int`l Univ
Texas A and M Univ
Texas A and M Univ, Commerce
Texas A and M Univ, Corpus Christi
Texas A and M Univ, Kingsville
Texas Christian Univ
Texas College
Texas Southern University
Texas Tech Univ
Texas Woman`s Univ
The American Col
The Art Institute of California - Los Angeles
The Boston Archit Center
The Cal Maritime Academy
The Catholic Univ of America
The Citadel
The Claremont Graduate School
The Col of New Jersey
The Johns Hopkins Univ
The Ohio St Univ
Thomas Col
Thomas Cooley Law School
Thomas Edison St Col
Thomas Jefferson Univ
Tougaloo College
Towson University
Transylvania Univ
Trenholm State Community College
Trinity Col
Trinity Int`l Univ
Trinity Univ
Tufts University
TUI University
Tulane Univ
Tuskegee University
UC, Berkeley
UC, Davis
UC, Hastings Col of Law
UC, Irvine
UC, Los Angeles
UC, Office of the President
UC, Riverside
UC, San Diego
UC, San Francisco
UC, Santa Barbara
UC, Santa Cruz
Union Col
University of Alabama
University of Alabama, Birmingham
University of Alabama, Huntsville
University of Alaska System
University of Alaska, Anchorage
University of Alaska, Fairbanks
University of Alberta
University of Arizona
University of Arkansas at Pine Bluff
University of Arkansas, Fayetteville
University of Arkansas, Little Rock
University of Arkansas, Monticello
University of Baltimore
University of Bridgeport
University of British Columbia
University of Calgary
University of Central Arkansas
University of Central Florida
University of Central Oklahoma
University of Charleston
University of Chicago
University of Cincinnati
University of Colorado
University of Colorado, CO Springs
University of Colorado, Denver
University of Connecticut
University of Dallas
University of Dayton
University of Delaware
University of Denver
University of Detroit Mercy
University of Dubuque
University of Evansville
University of Florida
University of Georgia
University of Guam
University of Guelph
University of Hartford
University of Hawaii
University of Houston
University of Houston, Clear Lake
University of Idaho
University of Ill at Chicago
University of Ill at Springfield
University of Ill at Urbana-Champaign
University of Indianapolis
University of Iowa
University of Judaism
University of Kansas
University of Kansas Medical Center
University of Kentucky
University of Louisville
University of Maine
University of Maine at Ft Kent
University of Maine System
University of Manitoba
University of Maryland at Baltimore
University of Maryland at Col Park
University of Maryland Eastern Shore
University of Maryland System
University of Maryland, Balt County
University of Mass at Amherst
University of Mass at Boston
University of Mass at Dartmouth
University of Mass at Lowell
University of Mass System
University of Med and Dentistry NJ
University of Memphis
University of Miami
University of Michigan-Ann Arbor
University of Michigan-Dearborn
University of Minnesota-Crookston
University of Minnesota-Duluth
University of Minnesota-Morris
University of Minnesota-Twin Cities
University of Mississippi
University of Missouri-Columbia
University of Missouri-Kansas City
University of Missouri-Rolla
University of Missouri-St. Louis
University of Montana, Missoula
University of N Dakota
University of N Dakota--Lake Region
University of N Florida
University of N Texas
University of NC at Asheville
University of NC at Chapel Hill
University of NC at Charlotte
University of NC at Greensboro
University of NC at Wilmington
University of Nebraska, Kearney
University of Nebraska, Lincoln
University of Nebraska, Omaha
University of Nevada Las Vegas
University of Nevada Reno
University of Nevada System
University of New Bruns., Fredericton
University of New Bruns., St John
University of New England
University of New Hamp, Durham
University of New Haven
University of New Mexico
University of New Orleans
University of Newport
University of North Texas
University of Northern Brit. Col.
University of Northern Colorado
University of Northern Iowa
University of Notre Dame
University of Oklahoma
University of Oregon
University of Ottawa
University of Penn
University of Phoenix
University of Pitt
University of Pitt at Johnstown
University of Portland
University of PR
University of PR, Mayaguez
University of PR, Rio Piedras
University of Puget Sound
University of Redlands
University of Regina
University of Rhode Island
University of Richmond
University of Rochester
University of S Alabama
University of S Carolina
University of S Carolina Upstate
University of S Carolina, Aiken
University of S Dakota
University of S Florida
University of San Diego
University of San Francisco
University of Saskatchewan
University of Scranton
University of Southern Cal
University of Southern CO
University of Southern Indiana
University of Southern Maine
University of Southern Mississippi
University of St. Thomas, Houston
University of St. Thomas, St. Paul
University of SW Louisiana
University of Tampa
University of Tenn, Chattanooga
University of Tenn, Knoxville
University of Tenn, Martin
University of Tenn, Memphis
University of Texas at El Paso
University of the District of Columbia
University of the Pacific
University of the South
University of the Virgin Islands
University of Toledo
University of Toronto
University of Tulsa
University of Utah
University of Vermont
University of Victoria
University of Virginia
University of W-Stevens Point
University of Washington
University of Waterloo
University of West Alabama
University of West Florida
University of West Georgia
University of Western Ontario
University of Winnipeg
University of Wisconsin-Eau Claire
University of Wisconsin-Green Bay
University of Wisconsin-La Crosse
University of Wisconsin-Madison
University of Wisconsin-Milwaukee
University of Wisconsin-Oshkosh
University of Wisconsin-Parkside
University of Wisconsin-Platteville
University of Wisconsin-River Falls
University of Wisconsin-Stout
University of Wisconsin-Superior
University of Wisconsin-Whitewater
University of Wyoming
Upper Iowa Univ
Ursinus Col
US Air Force Academy
US Coast Guard Academy
US Int`l Univ
US Merchant Marine Academy
US Military Academy
US Naval Academy
US Sports Academy
UT at Arlington
UT at Austin
UT at Brownsville
UT at Dallas
UT at Houston
UT at San Antonio
UT at Tyler
UT Health Center at Tyler
UT Medical Branch
UT SW Medical Center
UT-Pan American
Utah St Univ
Utah Valley St Col
Valdosta St Univ
Valley City St Univ
Valparaiso Univ
Vanderbilt Univ
Vassar Col
Vermont Technical Col
Villanova Univ
Virginia Commonwealth Univ
Virginia Military Inst
Virginia State University
Virginia Tech
Virginia Union University
Virginia University of Lynchburg
Virginia Wesleyan Col
Voorhees College
Wagner Col
Walden Univ
Warner University
Wartburg Col
Washington and Lee Univ
Washington Col
Washington St Univ
Washington Univ in St. Louis
Wayne St Univ
Weber St Univ
Webster Univ
Wellesley Col
Wentworth Inst of Tech
Wesley Col
Wesleyan College
Wesleyan Univ
West Texas A and M Univ
West Virginia State University
West Virginia Univ
Western Baptist Col
Western Carolina Univ
Western Conn St Univ
Western Illinois Univ
Western Kentucky Univ
Western Maryland Col
Western Michigan Univ
Western Montana Col
Western New England Col
Western Oregon St Col
Western St Col
Western Washington Univ
Wichita St Univ
Wilberforce University
Wiley College
Wilfrid Laurier Univ
Williams Col
Wilmington University
Winston-Salem State University
Wright State Univ
Xavier Univ, Cinci, OH
Xavier University of Louisiana
Yale Univ
Yeshiva Univ
York Univ
Grad School Major: (optional)
Accounting
Actuarial Science
Advertising
Aerospace Engineering
African Studies
African-American Studies
Agricultural Business and Management
Agricultural Economics
Agricultural Education
Agricultural Engineering
Agricultural Journalism
Agricultural Mechanization
Agricultural Technology Management
Agriculture
Agronomy
Air Force R.O.T.C.
American History
American Literature
American Studies
Animal Science
Anthropology
Applied Mathematics
Applied Physics
Arabic
Archeology
Architectural Engineering
Architectural History
Architecture
Army R.O.T.C.
Art
Art Education
Art History
Asian-American Studies
Astronomy
Astrophysics
Atmospheric Science
Aviation
Bakery Science
Biblical Studies
Biochemistry
Bioengineering
Biology
Biopsychology
Botany
Business Administration
Business Communications
Business Information Systems
Business Intelligence
Cell Biology
Ceramic Engineering
Ceramics
Chemical Engineering
Chemistry
Child Care
Child Development
Chinese
Chiropractic
Church Music
Circulation Technology
Civil Engineering
Classics
Clinical Psychology
Communication
Communication Disorders
Comparative Literature
Computer and Information Science
Computer Engineering
Computer Hardware Engineering
Computer Software Engineering
Computer Systems Analysis
Construction Management & Safety
Counseling
Creative Writing
Criminal Justice
Criminology
Crop Science
Culinary Arts
Dance
Data Processing
Developmental Psychology
Dietetics
Drawing
Early Childhood Education
East Asian Studies
East European Studies
Ecology
Economics
Education
Education Administration
Education of the Deaf
Educational Psychology
Electrical Engineering
Electronics
Electronics and Computer Technology
Elementary Education
Engineering Design
Engineering Mechanics
English
English Composition
English Literature
Entomology
Entrepreneurship
Environmental Engineering
Environmental Health Engineering
Environmental Science
Experimental Psychology
Fashion Design
Feed Science
Film
Finance
Food Science
Forensic Science
Forestry
French
General Studies
Genetics
Geography
Geological Engineering
Geology
German
Gerontology
Grain Science
Graphic Art
Great Books
Health Administration
Health Information Management
Hebrew
Historic Preservation
History
Home Economics
Horticulture
Hospitality
Human Development
Human Resources Management
Industrial Design
Industrial Engineering
Industrial Management
Industrial Psychology
Industrial Technology
Information Technology
Instructional Technology
Insurance
Interior Architecture
Interior Design
International Agriculture
International Business
International Relations
International Studies
Islamic Studies
Italian
Japanese
Jazz Studies
Jewish Studies
Journalism
Kinesiology
Landscape Architecture
Landscape Horticulture
Latin American Studies
Law
Library Science
Linguistics
Logistics Management
Management
Management Information Systems
Managerial Economics
Manufacturing Systems
Marine Corps R.O.T.C.
Marine Science
Marketing
Mass Communication
Mass Media Arts
Materials Science
Mathematics
Mechanical Engineering
Medical Technology
Medicine
Medieval and Renaissance Studies
Mental Health Services
Metallurgical Engineering
Microbiology
Middle Eastern Studies
Military Science
Mineral Engineering
Missions
Modern Greek
Molecular Genetics
Mortuary Science
Museum Studies
Music
Music History
Natural Resources Conservation
Naval Architecture
Navy R.O.T.C.
Neurobiology
Neuroscience
Nuclear Engineering
Nursing
Nutrition
Occupational Therapy
Ocean Engineering
Operations Management
Painting
Pastoral Studies
Peace Studies
Petroleum Engineering
Pharmacology
Pharmacy
Philosophy
Photography
Physical Education
Physical Therapy
Physics
Physiological Psychology
Piano
Plant Biology
Plant Pathology
Political Science
Portuguese
Poultry Science
Pre-Dentistry
Pre-Law
Pre-Medicine
Pre-Optometry
Pre-Seminary
Pre-Veterinary Medicine
Printmaking
Psychology
Public Administration
Public Health
Public Policy Analysis
Public Relations
Radio and Television
Radiologic Technology
Real Estate
Recreation Management
Rehabilatation Services
Religious Studies
Respiratory Therapy
Rhetoric
Risk Management
Rural Sociology
Russian
Sculpture
Slavic Languages and Literatures
Social Psychology
Social Work
Sociology
Soil Science
South Asian Studies
Southeast Asia Studies
Spanish
Special Education
Speech Pathology
Sport and Leisure Studies
Statistics
Substance Abuse Counseling
Surveying
Sustainable Resource Management
Teacher Education
Teaching English as a Second Language
Technical Writing
Technology Education
Telecommunications
Textile Engineering
Theatre
Theology
Turfgrass Science
Undecided
Urban Planning
Urban Studies
Visual Communication
Voice
Welding Engineering
Wildlife Management
Womens Studies
Youth Ministries
Zoology
Graduating Class: (optional)
1950
1951
1952
1953
1954
1955
1956
1957
1958
1959
1960
1961
1962
1963
1964
1965
1966
1967
1968
1969
1970
1971
1972
1973
1974
1975
1976
1977
1978
1979
1980
1981
1982
1983
1984
1985
1986
1987
1988
1989
1990
1991
1992
1993
1994
1995
1996
1997
1998
1999
2000
2001
2002
2003
2004
2005
2006
2007
2008
2009
2010
2011
2012
2013
2014
2015
2016
2017
2018
2019
2020
2021
2022
2023
2024
2025
2026
2027
2028
2029
Current Industry:
Accounting/Auditing
Administrative and Support Services
Advertising/Marketing/Public Relations
Agriculture, Forestry, & Fishing
Architectural Services
Arts, Entertainment, and Media
Aviation/Aeronautics
Banking
Biotechnology and Pharmaceutical
Broadcasting/Public Communications
Collegiate Faculty, Staff, Administration
Community, Social Services, and Nonprofit
Computers, Hardware
Computers, Software
Construction, Mining and Trades
Consulting Services
Counseling
Customer Service and Call Center
Development and Fund Raising
Employment Placement Agencies
Energy and Utilities
Engineering
Entrepreneurship
Environmental
Executive Management
Finance/Economics
Financial Services
Franchising
Government and Policy
Healthcare, Other
Healthcare, Practitioner and Technician
Hospitality/Tourism
Human Resources
Information Technology
Installation, Maintenance, and Repair
Insurance
Internet/E-Commerce
Law Enforcement, and Security
Legal
Logistics
Manufacturing and Production
Medical
Military
Natural Resources
Nonprofit and Volunteer Services
Other
Personal Care and Service
Publishing
Purchasing
Quality Control
Real Estate
Research & Development
Restaurant and Food Service
Retail/Wholesale
Sales
Science
Sports and Recreation
Teaching / K-12 Education
Telecommunications
Transportation
Video Game Development
Warehousing
Web Technology
Writing/Authoring
How Did You Hear About This Event:
Are You Open to Relocation:
Yes - I am Open to Relocation
No - Open to Remote or My Current Location
No - Only Remote Work Opportunities
Military Veteran:
Yes - Army
Yes - Air Force
Yes - Navy
Yes - Marine Corps
Yes - Coast Guard
No
I understand that by registering,
I am agreeing to the following Privacy Policy and Terms of Service .